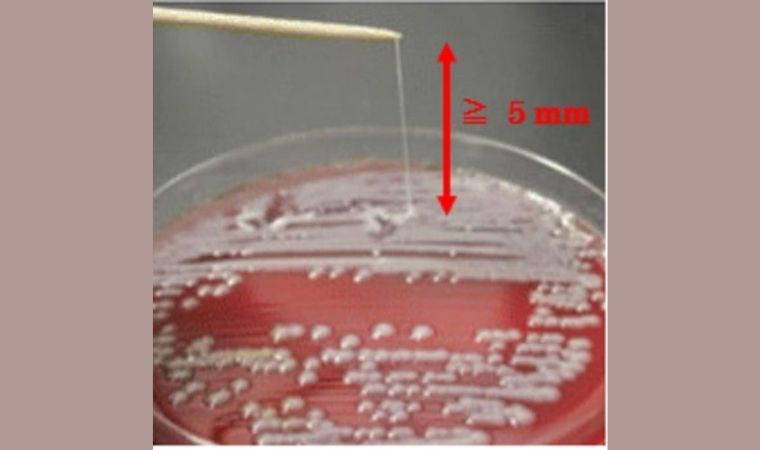

Savaşta yaralanan 150 kişiden aldıkları örnekleri test eden araştırmacılar, geniş spektrumlu antibiyotiklere dirençli bir dizi bakteri türü buldu, bu bakterilerin yüzde 6'sı test edilen tüm antibiyotiklere direnç gösteriyordu.
Klebsiella pneumoniae bakterisinin daha geniş kapsamlı hastalıklara yol açıp açmadığını değerlendirmek için bu bakterinin örneklerine yoğunlaştılar. Klebsiella, zatürreyle idrar yolu, deri ve yara enfeksiyonları gibi bir dizi hastalığa yol açıyor ve antibiyotiklere dirençli bakterilerin neden olduğu tüm ölümlerin 5'te birine yakınının kaynağı.
Independent Türkçe'nin haberine göre bilim insanları, ilaca dirençli bakterileri olduğu bilinen 37 hastadan alınan numuneleri inceleyerek bakterinin genomunu diziledi. Araştırmanın yazarlarından Kristian Riesbeck "Tüm bakterilerin dirençle ilişkili olduğunu bildiğimiz genleri taşıdığı görüldü" dedi.
Bunların 4'te birinin piyasadaki tüm antimikrobiyal ilaçlara dirençli olduğunu gördük. Bu tür bakterilerin tamamen dirençli olduğu söyleniyor.
Bilim insanları, bu tür süper bakterilerin antibiyotiklere aşırı seviyede direnç gösterdiğini ve "sağlık hizmetlerinde artan bir endişeye yol açtığını" belirtti.
İsveç'in Lund Üniversitesi'nden araştırmacılar da dahil olmak üzere bilim insanları, bu bakterilerin yol açtığı enfeksiyonların tedavisinin "çok zor" olabileceği konusunda uyardı.
Dr. Riesbeck, Science'a Klebsiella enfeksiyonlarının tedavisinin zor olmasının bir nedeninin de "olağanüstü" miktarda mukus üretmeleri olduğunu açıkladı.
Bazı durumlarda bunun "halihazırda elimizdeki ilaçlarla tedavinin imkansız olabileceğini" söyledi.
Bilim insanları, fareler ve böcek larvaları üzerinde yapılan bir deneyle Ukrayna'daki hastalardan alınan bakterilerin enfeksiyonu daha fazla yayıp yayamayacağını da sınadı.
"Antibiyotiklere en dirençli bakteri türleri, zatürreyle bağlantılı bir şekilde farelerde de en iyi hayatta kalanlardı" dediler.
Bu bakteri türleri, benzer bir şekilde böcek larvalarını antibiyotiklere daha az dirençli olan bakterilerden çok daha hızlı öldürecek kadar saldırgandı.
Araştırmacıların incelediği tam dirence sahip tüm Klebsiella bakterilerinin, kendilerini daha saldırgan hale getiren genler taşıdığı tespit edildi.
Dr. Riesbeck "Belki de bakterileri hafife aldık. Ukrayna'daki bu bakteri türlerinin birçoğunun kendilerini hem dirençli hem de saldırgan kılan genlere sahip olduğunu gördük" dedi.
Dr. Riesbeck "Tüm ilaçlara direnç gösteren bu bakteriler, antibiyotik tedavilerimizden sağ çıkmaya çalışırken hala hastalığa yol açabilecek eksiksiz bir gen setine sahip. Bu hepimiz için şaşırtıcı ve ne yazık ki gelecek için endişe verici bir işaret" dedi.
Araştırmacılar, Ukrayna'da yaralılar arasında yayılan bu tür bakterilerin hayatta kalmayı sürdürme ve sorun yaratma ihtimalinin yüksek olduğuna dair uyardı. Bilim insanları "Endişe verici bir şekilde, bulgularımız Ukrayna'daki savaş mağdurlarının birçok ilaca dirençli ve aşırı saldırgan K pneumoniae'den etkilendiğine işaret ediyor" yazdı.
Bu zamanla ortadan kaybolacak bir şey değil. Hastalar izole edilip uygun bir şekilde tedavi edilemedikçe enfeksiyon yayılmaya devam edecek.